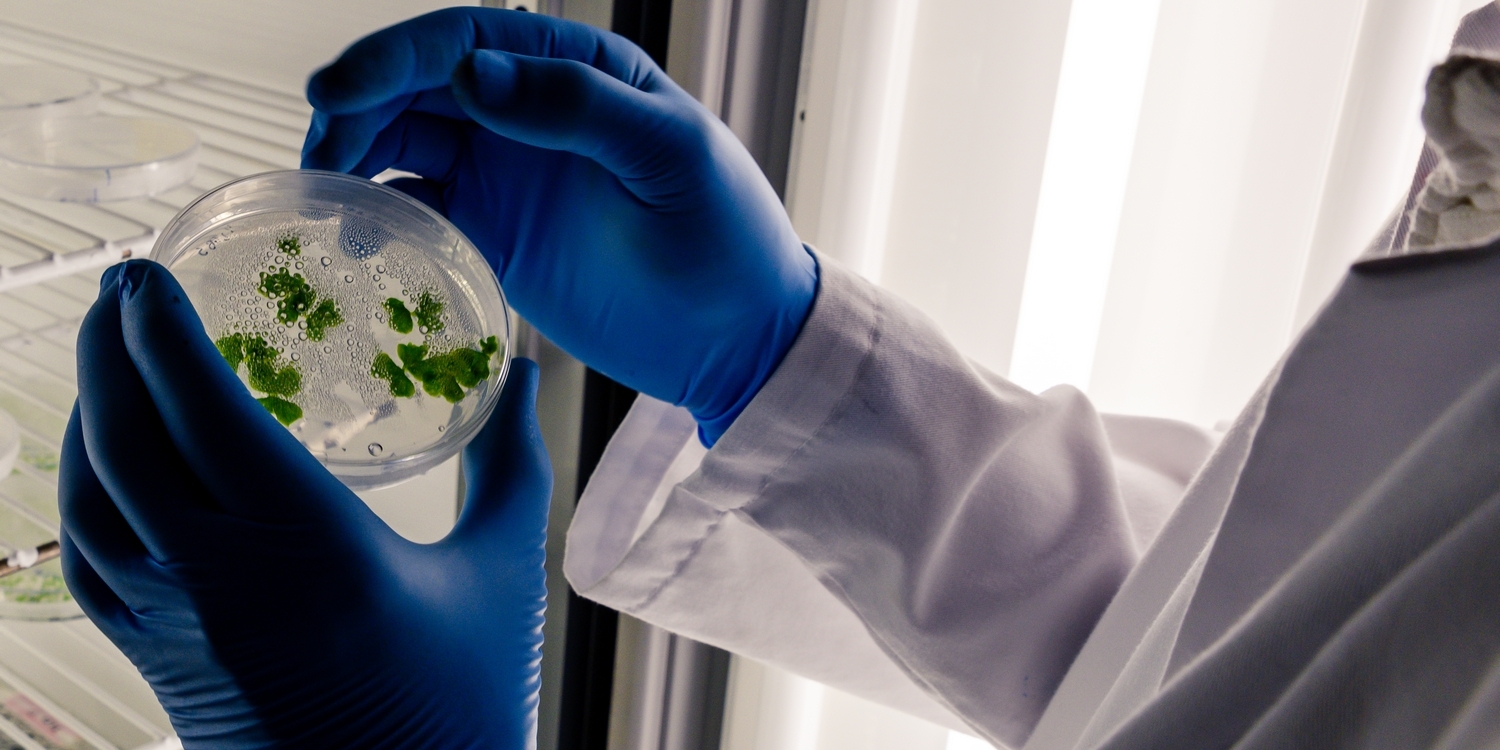
руки лаборанта в синих перчатках держат чашку Петри с растениями

Всем привет, на связи Сергей, и мы продолжаем нашу интересную беседу о микроклональном размножении растений. Больше материалов по данной теме вы можете найти в специальном разделе нашего сайта — микроклональное размножение растений.
Вместо введения
Сегодня я хочу рассказать о самой первой искусственной питательной среде, созданной для клонирования растений. Термин «питательная среда» чётко отражает смысл своего названия. Благодаря питательной среде растения могут не только продолжать своё существование, но и превращаться в самостоятельные организмы с корнями, стеблями и листьями. По своему составу питательная среда максимально похожа на внутренний химический состав растения, если говорить точнее — жидкостей внутри него. При микроклональном размножении используются довольно маленькие кусочки растений. Сами по себе эти кусочки практически нежизнеспособны. Если вы поместите их в почву или в обычную воду, все их клетки погибнут очень быстро и ничего из них не вырастет. Искусственная питательная среда «обманывает» клетки эксплантов и как бы сообщает им о том, что они находятся внутри растения, питания достаточно и можно расти и развиваться. Согласитесь, повторить химический состав жидкостей растения — задача не из простых, тем не менее, двум учёным удалось это сделать в далёком уже 1962 году.
Тосио Мурасиге родился на Гавайях в 1930 году. В 1952 году он получил степень бакалавра в Гавайском университете. А через шесть лет — степень доктора в Висконсинском университете. Большую часть времени он проработал в Калифорнийском университете в Риверсайде. Доктор Мурасиге до сих пор жив, хоть и находится уже в весьма преклонном возрасте.
Карл Фолке Скуг родился 15 июля 1908 года в шведской провинции Халланд. В далёком 1925 году Карл Скуг эмигрировал в США и трудился там в нескольких университетах. Интересно, что учёный принимал участие в Олимпийских играх 1932 года и занял второе место в забеге на 1500 м. А в 1936 году Скуг получил докторскую степень в Калифорнийском университете. Кстати, его докторская работа была посвящена ауксинам. Начиная с 1937 года Скуг принимал самое активное участие в открытии новых и изучении уже известных растительных гормонов. Например, в его лаборатории был открыт, а затем синтезирован химическим путём бензиладенин — вещество, родственное кинетину. В 1991 году Скуг был награждён Национальной медалью науки Швеции. Умер учёный 15 февраля 2001 года, прожив долгую и очень насыщенную жизнь.
Как вы уже догадались, именно по фамилиям этих учёных и была названа первая искусственная питательная среда для микроклонального размножения растений. В 1962 году Мурасиге и Скуг опубликовали самую известную на сегодня работу касательно культуры тканей. К тому моменту учёные бились над поиском «самого главного вещества роста растений». В качестве подопытных использовались растения табака. Учёные применяли различные способы стимулирования роста этих растений. В том числе они использовали различные экстракты из них же. В этих экспериментах учёными было установлено стимулирующее воздействие на рост растений вытяжки из свежих табачных листьев, полученной особым образом. Но на этом научно-исследовательская работа не остановилась. Учёные сжигали растения табака и проводили глубокий анализ состава золы. К исследованию золы их подтолкнуло то, что зола, полученная от сжигания табака, тоже оказывала на растения стимулирующий эффект. Учёные досконально изучили химический состав растений табака на всех стадиях их жизни.
Такая глубокая аналитическая работа привела к тому, что были получены количественные значения всех химических веществ, содержащихся в тканях растений табака. Дело осталось за малым — повторить состав среды. Учёные провели большое количество экспериментов и представили миру рецепт питательной среды, который сегодня является самым универсальным в области микроклонального размножения растений.
Если вы начнёте искать точный состав питательной среды Мурасиге — Скуга, то в русскоязычном сегменте интернета вам попадётся с десяток разных вариантов. И во всех этих вариантах количество макро- и микроэлементов будет разным. Также будет отличаться состав и концентрация гормонов и сахарозы. Дело в том, что каждый вид растений имеет свои определённые особенности, по-разному реагирует на кислотность среды, имеет свою скорость метаболизма. Растения могут быть более или менее требовательны к отдельным компонентам питательной среды и другим условиям. Так что универсальная формула питательной среды существует, но она может видоизменяться в зависимости от особенностей растений, которые мы размножаем.
Сейчас у начинающего микробиолога есть два пути по подбору питательных сред. Первый путь — простой. В этом варианте мы начинаем искать в интернете состав питательной среды для микроклонального размножения конкретного растения. Например, если вы решите размножать клубнику, то найдёте несколько типов питательных сред для неё. В протоколе размножения будет подробно описано, в каких случаях следует применять те или иные составы питательной среды и из каких компонентов она состоит. Второй путь сложнее, по нему придётся пойти в том случае, если до вас никто не описал клонирование нужного вам растения. Обычно такое происходит с не очень популярными растениями. Например, сейчас набирают массовую популярность суккуленты. Их разведение, кстати, отлично вписывается в концепцию сити-фермерства. А если подобрать редкие сорта, то на этом можно очень хорошо заработать. Ведь стоимость некоторых суккулентов может достигать нескольких сотен, а то и тысяч долларов. Сейчас очень активно микроклональным способом размножают редкие хавортии, литопсы, вариегатные крассулы и другие суккуленты. Лидеры в этом, пожалуй, китайцы. И они, по понятным причинам, не очень активно делятся технологиями размножения. Вернее, они ими совсем не делятся. Размножают суккуленты китайские практики, и у них нет ни времени, ни желания описывать протоколы размножения конкретных растений, тем более что это приведёт к ненужной им конкуренции.
В случае если вы не нашли протокола размножения конкретного растения, то придётся идти по более сложному пути. Для начала мы ищем протоколы размножения похожих растений и их берём за основу. Но готовим сразу три–пять вариантов питательной среды, меняя концентрацию солей, гормонов и сахарозы. Далее осуществляем высадку эксплантов на все среды и наблюдаем, где будет самый хороший рост (или будет хоть какой-то рост эксплантов). Далее отбраковываются нерабочие питательные среды и проводится улучшение рабочих. Работа проводится с изменением концентрации веществ в питательной среде. На этом этапе очень важно фиксировать все успехи и неудачи и проводить подробный их разбор. Это поможет получить рабочий питательный раствор в самые короткие сроки.
Хочу обратить ваше внимание на то, что вся научная работа касательно клонирования растений ведётся на Западе и в Китае. Не пытайтесь искать протоколы клонирования на русском языке. Конечно, в нашей стране тоже ведутся работы по изучению клонирования растений, но в свете малого финансирования публикаций по таким работам очень мало. Так что всю информацию следует искать в англоязычном сегменте интернета среди агрегаторов научных статей. И ещё одно предостережение: всегда перепроверяйте информацию. Например, мне попадалась методичка, изданная известным российским вузом, в которой концентрация одной из макросолей была указана с превышением в 10 раз (просто напечатали лишний ноль). Понятно, если смешать такую питательную среду, то на ней ничего не вырастет. Так что, прежде чем приступать к конкретным действиям, следует очень ответственно подойти к сбору и анализу первичной информации. Очень полезно найти сообщества единомышленников, например, в русскоязычном сегменте оно немногочисленно, наберётся едва ли человек 80, зато люди открыты и, если могут помочь, — обязательно это делают. Чуть лучше ситуация в англоязычном сегменте — есть несколько крупных профильных форумов.
Состав питательной среды Мурасиге — Скуга
Любая питательная среда для микроклонального размножения растений состоит из нескольких условных групп веществ:
- макроэлементы (макросоли),
- микроэлементы (микросоли),
- хелат железа,
- витамины и органические вещества,
- сахароза,
- агар-агар,
- дистиллированная вода.
Как можно увидеть, состав довольно разнообразный, и это тоже вносит свои сложности в приготовление раствора. Стоит сказать, что в продаже имеются готовые наборы с уже взвешенными веществами, которые нужно растворить в воде, следуя инструкции, и затем стерилизовать. Но такие наборы, во-первых, производятся в недружественных странах, и на момент выхода статьи найти их в наличии в России довольно сложно. А во-вторых, стоят они существенно дороже в сравнении с вариантом купить всё отдельно и смешать самостоятельно. Кроме того, готовые питательные среды можно поискать в сообществах микробиологов. Плюсом будет то, что вы сможете найти даже стерильную питательную среду, расфасованную по контейнерам и готовую к использованию. Далее я подробно опишу оригинальный состав питательной среды Мурасиге — Скуга для размножения орхидей.
Макроэлементы и микроэлементы (макросоли и микросоли) питательной среды Мурасиге — Скуга
Микро- и макроэлементы, входящие в состав питательной среды для клонирования растений, представляют собой неорганические вещества. Все эти вещества растворимы в воде. В этой статье я приведу состав среды Мурасиге — Скуга, предназначенной для размножения орхидных умеренной климатической зоны, а в следующих материалах опишу подробно нюансы смешивания питательных сред. Макроэлементы — это «кирпичи» — строительный материал, из которого образуются новые клетки растения. А микроэлементы можно сравнить с раствором, на который всё собирается. И без этого «раствора» построить дом не получится.
Макроэлементы Мурасиге — Скуга
В состав питательной среды Мурасиге — Скуга для размножения орхидных входят следующие макросоли:
- нитрат калия KNO3 — 1900 мг/л;
- хлорид кальция CaCl2*2H2O — 440 мг/л;
- нитрат аммония NH4NO3 — 1650 мг/л;
- дигидрофосфат калия KH2PO4 — 170 мг/л;
- сульфат магния MgSO4*7H2O — 370 мг/л.
Как правило, количество макросолей в питательном растворе — величина постоянная, хотя и тут могут быть особенности. Если вы берёте в размножение растение, по которому нет прописанного состава питательной среды, всегда используйте базовый набор макросолей.
Хелат железа в питательной среде Мурасиге — Скуга
Железо — один из важнейших элементов жизни на нашей планете. В растениях железо является важнейшим компонентом зелёных пластид — хлоропластов. Железо отвечает за клеточное дыхание, участвует в синтезе хлорофилла, в обмене серы, азота и других веществ. В чистом виде и в виде оксидов железо не может быть усвоено растениями. При дефиците железа у растений начинаются системные проблемы, их финал — хлороз и гибель растения. Самая эффективная форма железа с точки зрения биодоступности — его хелат. И именно хелат железа добавляют во все питательные среды.
- Сульфат 7-водного железа FeSO4*7H2O — 27,95 мг/л.
- Железная соль этилендиаминтетрауксусной кислоты C10H12FeN2NaO8 — 37,23 мг/л.
Микроэлементы питательной среды Мурасиге — Скуга
Микроэлементы обычно называют микросолями или минорными солями. Как правило, это соединения необходимых растению веществ, таких как медь, марганец, цинк и другие. Минорные соли имеют очень важное значение, большинство из них незаменимы, и без них жизнь растения невозможна. Как правило, эти вещества добавляются в питательную среду в довольно низких концентрациях. Для их взвешивания нужны точные лабораторные весы с возможностью взвешивать тысячные и десятитысячные доли миллиграмма. Превышение количества этих веществ, как и их недостаток, является критичным в процессе микроклонального размножения растений. В состав питательной среды Мурасиге — Скуга входят следующие минорные соли:
- хлорид кобальта CoCl2·6Н2О — 0,025 мг/л;
- сульфат цинка ZnSO4·7H2О — 8,6 мг/л;
- борная кислота Н3ВО3 — 6,2 мг/л;
- сульфат марганца(II) MnSO4·5Н2О — 22,3 мг/л;
- сульфат меди(II) CuSO4*5Н2О — 0,025 мг/л;
- молибдат натрия Na2МoО4*2Н2О — 0,25 мг/л;
- йодид калия КІ — 0,83 мг/л.
Витамины и органические вещества, входящие в состав питательной среды Мурасиге — Скуга
Теперь мы переходим в область органической химии. Микро- и макроэлементы растения получают извне, из субстрата. И из этих элементов растения, как настоящие биофабрики, синтезируют необходимые им органические питательные вещества. Кусочек растительной ткани, который мы помещаем на питательную среду для клонирования, не является полноценным растением. Как правило, этот набор однотипных клеток, меристемных, или, например, каллусных (могут быть и другие варианты). И эти клетки не то что не способны к полноценному органическому синтезу, они не способны самостоятельно существовать в открытой среде. Да и сами эти клетки нуждаются в питании, которое не могут производить самостоятельно, и это питание они могут получить только из нашего искусственного субстрата — питательной среды. В состав питательной среды Мурасиге — Скуга входят следующие органические вещества:
- глицин — 2 мг/л;
- мезоинозит (мио-инозитол, витамин B8) — 100 мг/л;
- никотиновая кислота (витамин PP) — 0,5 мг/л;
- тиамин (витамин B1) — 0,1 мг/л;
- пиридоксин (витамин B6) — 0,5 мг/л;
- гидролизат лактальбумина (опционально) — 1 мг/л.
Отмечу, что гидролизат лактальбумина присутствует в изначальной рецептуре среды Мурасиге — Скуга, но используется не всегда. Например, в смеси для выращивания орхидей он не используется. В питательную среду Мурасиге — Скуга могут входить и другие органические соединения, вроде гидролизата казеина или фолиевой кислоты. Всё зависит от внутреннего химического состава растения, которое мы планируем клонировать. Всегда нетипичные элементы питательной среды указываются отдельно в протоколе создания питательной смеси. В питательную среду могут быть добавлены фунгициды и антибиотики, в том числе органической структуры.
Сахароза в составе питательной среды Мурасиге — Скуга
Сахароза относится тоже к классу органических веществ, но обычно в описании состава питательной среды этот компонент указывается отдельно. Сахароза относится к дисахаридам, её молекула состоит из двух простых моносахаридов альфа-глюкозы и бета-фруктозы. Глюкоза является источником общедоступной энергии не только для растений, но и для млекопитающих, в том числе людей. Глюкозу можно отнести к базовым органическим веществам жизни на нашей планете. Фруктозу можно назвать природным сахаром (хоть и простым), и она синтезируется практически всеми растениями. Часто большое количество фруктозы и других растительных сахаров накапливается в плодах растений. Это делает плоды более вкусными и интересными для потенциальных переносчиков семян — животных. В качестве примера ещё можно привести пчёл, желая полакомиться сладким нектаром (читайте набором сахаров) из цветов, эти трудолюбивые насекомые проводят опыление растений.
Сахароза и её моносахара являются основными строительными и транспортными элементами растений. Сахароза и моносахара очень легко разрушаются, в процессе чего отдают углерод и довольно большое количество энергии. Энергия уходит на обеспечение жизнедеятельности растения, а углерод, соединяясь с другими веществами, становится строительными кирпичиками ткани растения. Именно поэтому сахара обязательно входят в состав всех сред для клонирования растений. И среда Мурасиге — Скуга является чемпионом по содержанию сахарозы:
- сахароза C₁₂H₂₂O₁₁ — 30 000 мг/л.
В других питательных средах может использоваться фруктоза или глюкоза, чаще в меньшей концентрации.
Обычный сахар, который продают в магазинах и который мы едим каждый день, по своей сути и есть сахароза, полученная из сахарной свёклы или сахарного тростника. Сейчас есть мода на коричневый тростниковый сахар, который представляет собой сахарозу слабой очистки. Бывает и немного тёмный свекольный сахар. По идее, за неимением другого мы можем использовать белый рафинированный сахар, купленный в магазине. Для нас не очень важно, был ли произведён сахар из тростника или из свёклы, после очистки и кристаллизации мы получим сахарозу, идентичную по химическому строению и составу.
Для маркировки обычного сахара по ГОСТ используют следующие обозначения:
- СВ, С — сахар, произведённый из свёклы;
- СС, Т, СТ — сахар, произведённый из тростника.
Также сахар подразделяется по степени очистки на четыре категории:
- Экстра, высшее качество или экстрабелый сахар. В таком сахаре массовая доля сахарозы составляет не менее 99,8%.
- Белый сахар категории ТС1 и ТС2. Эти категории отличаются разными допусками к содержанию влаги, редуцирующих веществ и цветности. Содержание сахарозы в этих категориях одинаково и составляет 99,7%.
- Фабричный сахар категории ТС3. Пожалуй, это самая распространённая категория сахара в наших магазинах. У этого сахара можно заметить желтоватый оттенок и слабый запах мелассы. Сахарозы в таком сахаре должно быть не менее 99,5%.
Категории сахара ТС2 и ТС3 могут слёживаться и образовывать комки, для сахара класса «Экстра» и ТС1 слёживание и образование комков не допускается.
За неимением лучшего начинающий микробиолог может использовать для питательной среды сахар категорий «Экстра» или ТС1. Стоит сказать, что и опытные микробиологи часто поступают так же. Другие категории могут нести в себе сторонние вещества, которые с высокой долей вероятности повлияют на культивируемые эксплантаты.
Но если вы хотите сделать все «по-правильному», то вам нужно искать сахарозу с маркировкой ЧДА, а ещё лучше ХЧ. Аббревиатура ЧДА (ч.д.а.) расшифровывается как «чистое для анализа» и говорит о том, что в исходном продукте содержится не менее 98% нужного вещества. ХЧ (х.ч.) расшифровывается как «химически чистое» и говорит о том, что в продукте содержится менее 1% примесей, или вещество на 99% и более чистое.
По идее под ЧДА и даже под ХЧ у нас попадают все категории сахара из ГОСТа. Но по факту всё, что продаётся в наших магазинах, вряд ли будет лучше 4-й категории по ГОСТу.
В среде Мурасиге — Скуга в качестве питательного элемента используется именно сахароза, её замена на фруктозу или глюкозу не допускается. Объяснить это можно довольно высокой универсальностью данной среды для клонирования разных растений. Как я писал выше, молекула сахарозы довольно легко разделяется на моносахара. На разных стадиях жизни растения его клеткам в качестве питания требуется или фруктоза, или глюкоза, и мы перекрываем эту потребность сахарозой, которая, кстати, тоже легко усваивается растительными клетками.
Агар-агар в составе питательной среды Мурасиге — Скуга
В процессе микроклонального размножения растений экспланты могут помещаться в жидкие или на твёрдые среды. Существенная часть растений не способна к микроклональному размножению в жидких средах. Да, растение может пустить корни, находясь в жидкой среде, но, учитывая особенности замкнутого стерильного контейнера или пробирки, большинство растений просто погибнут, если не попадут на твёрдый субстрат. Для получения твёрдых субстратов используют агар-агар. Получают это вещество из нескольких видов высших водных растений (по-простому можно сказать — водорослей, но с точки зрения биологической систематики это неправильно). По внешнему виду агар — желтовато-белый порошок, иногда пластинки в виде лёгких и тонких хлопьев. В составе агар-агара можно выделить следующие основные компоненты:
- минеральные соли,
- вода (в связанном виде),
- полисахариды (их там целый набор).
По своим свойствам агар-агар является растительным гелеобразователем. Его активно используют в микробиологии и пищевой промышленности. Хотя в пищевой промышленности агар-агару очень трудно конкурировать с желатином — животным гелеобразователем. Желатин более доступен и дёшев в производстве. Но для микроклонального размножения растений желатин не годится.
Молекулы агар-агара представляют собой очень длинные цепочки органических соединений. Такое строение делает молекулы очень прочными. Агар-агар может растворяться только в горячей воде, в коридоре температур от 95 до 100 градусов Цельсия. Разогретый раствор агара довольно прозрачен и не сильно вязок. Но при снижении температуры до 30–40 градусов по Цельсию агар-агар твердеет и превращает жидкость, в которой он растворён, в студнеобразный гель. Плотность геля зависит от концентрации агар-агара. Интересно, что гелеобразование с помощью агар-агара является обратимым процессом, если полученный гель снова нагреть до температуры 80–95 градусов, то он станет жидким и снова затвердеет при снижении температуры.
Плотность получаемого геля зависит от концентрации агар-агара. По степени плотности в микробиологии выделяют три вида сред:
- жидкие среды или бульоны,
- полужидкие среды,
- твёрдые среды.
В жидких средах гелеобразователь отсутствует. Кстати, возможно, жидкие среды готовили и вы, даже не имея отношения к микробиологии. Например, если вы смешивали стимулятор корнеобразования с водой и затем в полученный раствор помещали черенки для укоренения, то вы как раз делали жидкую питательную среду. Жидкие среды довольно часто используют в условиях лабораторий микроклонального размножения.
Для получения полужидких сред используют 0,3–0,7% агар-агара от общего объёма питательной среды. В твёрдых средах содержится от 1,5 до 3% гелеобразователя.
Для получения питательной среды Мурасиге — Скуга в качестве гелеобразователя необходимо использовать:
- агар-агар (C12H18O9) — 10 000 мг/л.
В процессе подготовки питательных сред для микроклонального размножения растений следует обращать внимание на химическую чистоту ингредиентов. Условно, у пищевого агара выделяют всего два сорта, критерием является степень очистки и, как следствие, цвет.
- Агар-агар высшего сорта. Это вещество с довольно высокой степенью очистки, обычно белого цвета, допускается немного жёлтый или немного серый оттенок.
- Агар-агар первого сорта. Это вещество уже имеет насыщенный жёлтый цвет.
Но существует и третий вид — микробиологический агар-агар. От предыдущих он отличается степенью очистки. И я рекомендую использовать именно его. Особенно, если вы находитесь в начале пути. Так вы сможете исключить случайные неудачи, вызванные загрязнениями питательной среды лишними веществами.
Также следует отметить, что агар-агар чувствителен к pH среды. При слишком кислой или слишком щелочной реакции желирование раствора может не произойти.
PH питательной среды Мурасиге — Скуга
Показатель pH является одним из самых основных при выращивании растений. Дело в том, что, если субстрат или вода для полива будут иметь слишком кислотную или слишком щелочную реакцию, у растения произойдёт блокировка питания. Не важно, сколько удобрений вы будете вносить, большинство растений не способны полноценно существовать при показателе pH меньше 5 и больше 7 единиц, есть исключения, но их довольно мало.
У питательной среды Мурасиге — Скуга показатель pH должен быть равен 5,7 единиц, по крайней мере, если вы собрались размножать орхидные растения средней полосы. Для других растений показатель pH обычно указывают в протоколе размножения. Напомню, для большинства растений этот показатель должен находиться в коридоре от 5,5 до 6,5 единиц.
Иногда изменение показателя pH на одну-две десятые единицы может быть критичным при микроклональном размножении. Так что если вы пытаетесь размножить растение, которое до вас никто не размножал, и дела у вас идут не очень хорошо — проверьте кислотность среды и попробуйте разные её варианты с шагом в одну-две десятые единицы.
На этом, пожалуй, можно закончить рассказ о составе и особенностях питательной среды Мурасиге — Скуга. В дальнейших статьях я обязательно расскажу вам про составы других питательных сред, используемых в микроклональном размножении растений, а также об их стерилизации и других особенностях. Всем больших урожаев!